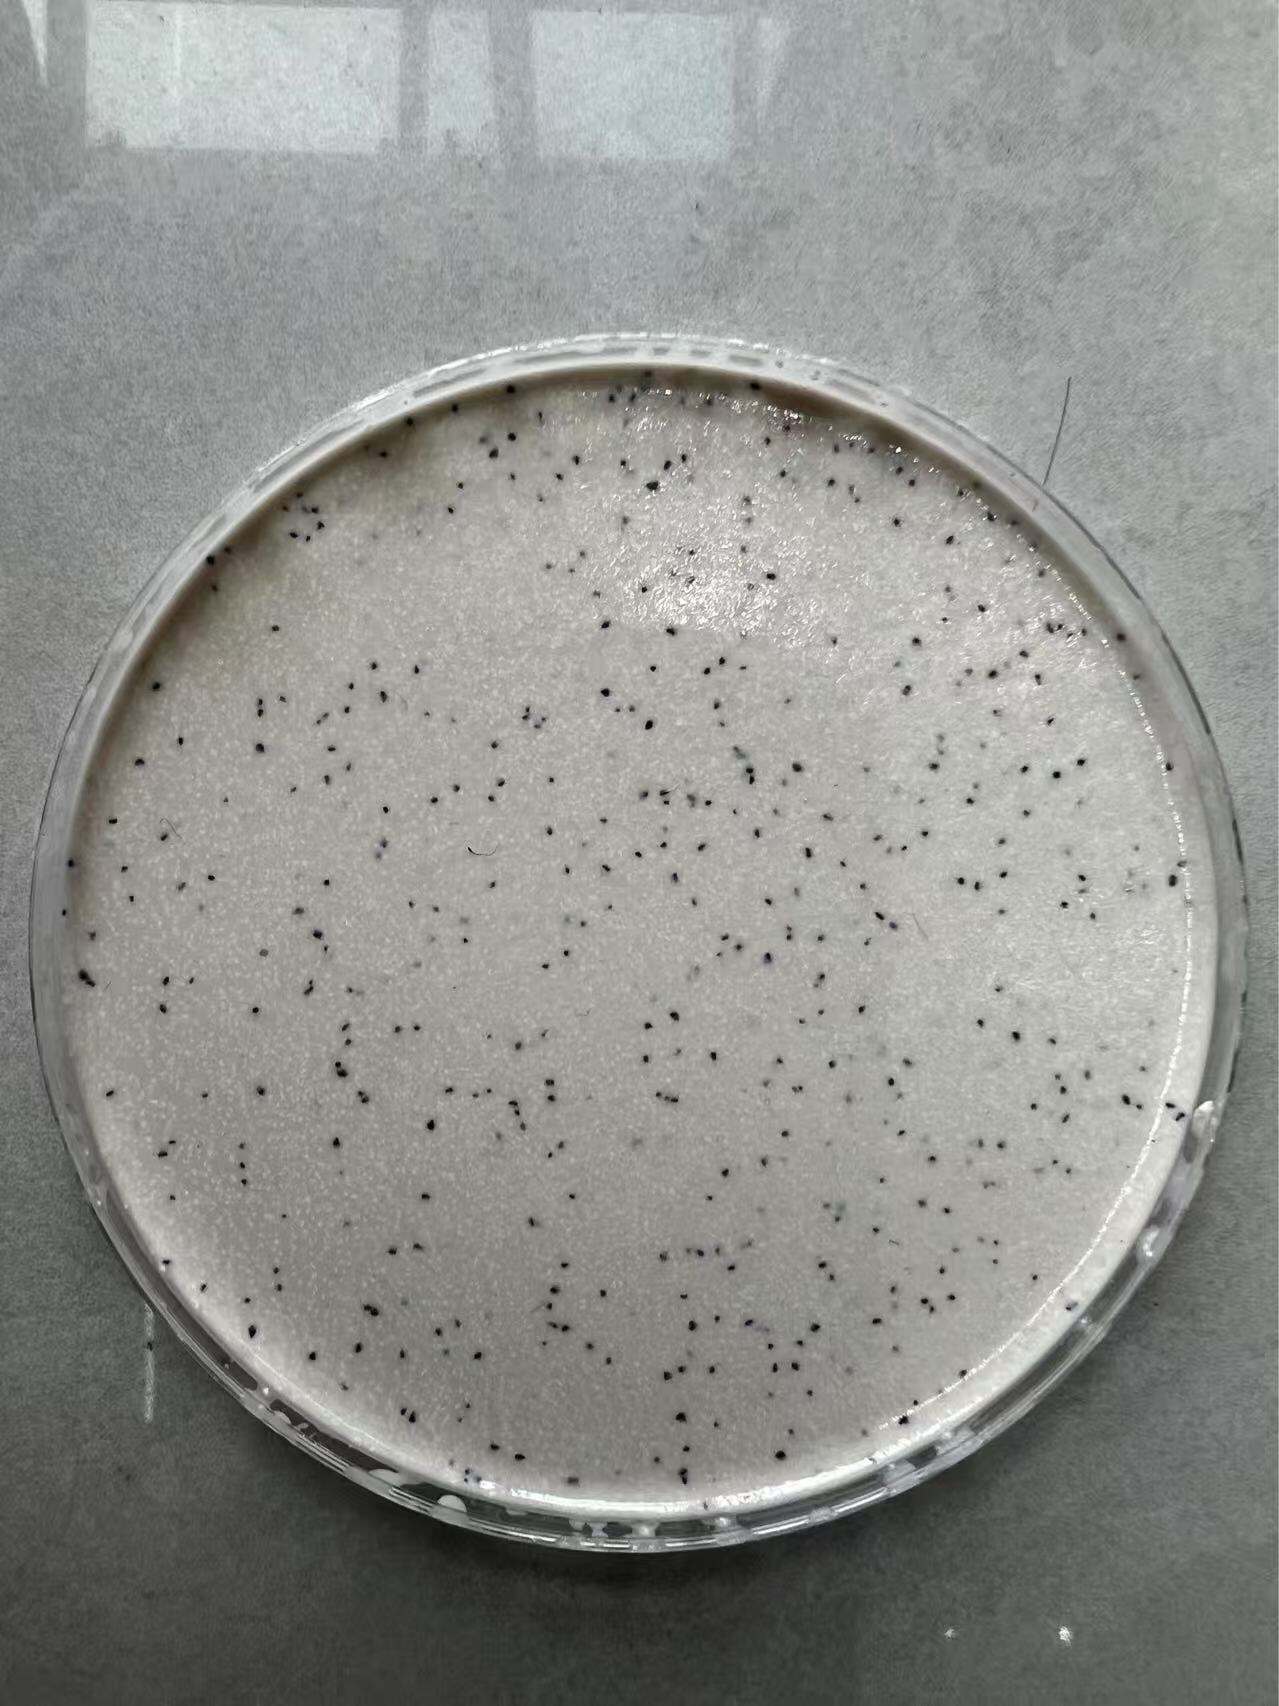
Aplicaciones versátiles y proceso de instalación sencillo

recubrimiento antideslizante EPDM
El recubrimiento antideslizante de EPDM representa una solución revolucionaria para pavimentos que combina seguridad y durabilidad en entornos comerciales y residenciales. Este sistema avanzado de recubrimiento utiliza la tecnología del monómero de etileno-propileno-dieno (EPDM) para crear superficies que reducen significativamente los riesgos de deslizamiento, manteniendo al mismo tiempo una excepcional longevidad. La función principal del recubrimiento antideslizante de EPDM consiste en transformar superficies lisas, potencialmente peligrosas, en pasillos seguros que cumplen con estrictas normativas de seguridad. El recubrimiento actúa incorporando áridos especializados y elementos texturizados que incrementan la fricción superficial, proporcionando una tracción fiable incluso en condiciones húmedas. Las formulaciones modernas de recubrimiento antideslizante de EPDM ofrecen una excelente resistencia climática, estabilidad química y protección frente a los rayos UV, lo que garantiza un rendimiento constante en diversas condiciones ambientales. El marco tecnológico subyacente a este recubrimiento implica una sofisticada química de polímeros que genera películas superficiales flexibles pero robustas. Estas películas se adhieren de forma permanente a sustratos como hormigón, metal, madera y revestimientos de suelo existentes. Los profesionales de la instalación aplican el recubrimiento antideslizante de EPDM mediante técnicas especializadas que aseguran una cobertura uniforme y unas características óptimas de adherencia. La estructura molecular del recubrimiento ofrece una excelente resistencia a las fluctuaciones de temperatura, evitando grietas o deslamination durante los cambios estacionales. Las aplicaciones del recubrimiento antideslizante de EPDM abarcan múltiples industrias y entornos. Las cocinas comerciales se benefician de sus propiedades resistentes a la grasa, que mantienen la antideslizante a pesar de las intensas operaciones de servicio alimentario. Las instalaciones industriales utilizan este recubrimiento en pasarelas, rampas y zonas de carga, donde la seguridad de los trabajadores es primordial. Las zonas alrededor de piscinas, áreas de duchas y centros balnearios confían en el recubrimiento antideslizante de EPDM para prevenir accidentes en entornos constantemente húmedos. Los establecimientos minoristas aplican esta tecnología cerca de las entradas y zonas de alto tráfico, donde la humedad procedente del exterior crea condiciones peligrosas. Los centros sanitarios dependen del recubrimiento antideslizante de EPDM en pasillos, salas de tratamiento y zonas de pacientes, donde los dispositivos de asistencia para la movilidad requieren superficies con tracción fiable.